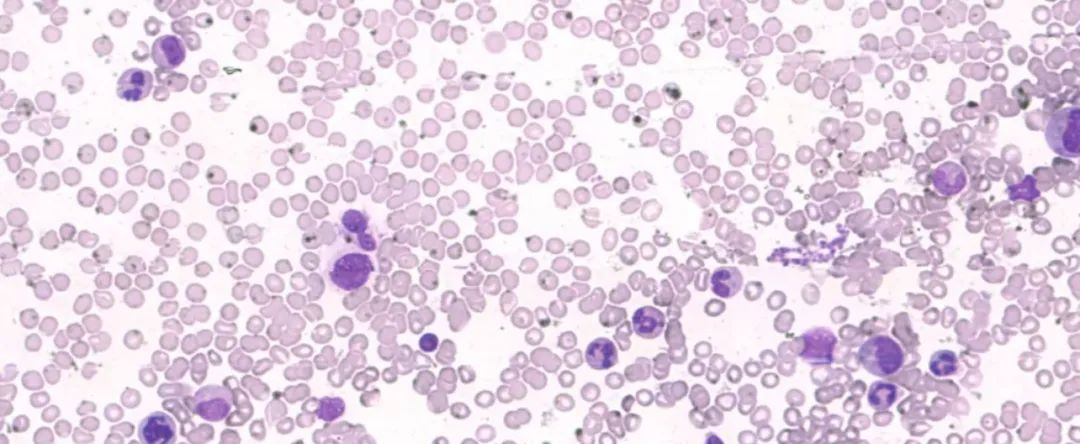

快鲤鱼周报:本周最值得关注的7家新创公司!

知了背调

观脉科技

能源汇
能源汇是一家基于能源产业互联网平台的数字化橇装式加油连锁品牌,同时也是行业率先利用前置仓,以自营模式切入成品油产业链的互联网加油连锁品牌。

送好多

5
蓝晶微生物

爱华盈通

智微信科
智微信科是一家专业从事人工智能形态学检验和病理诊断的高科技公司,其自主研发的人工智能骨髓细胞形态学分析诊断系统,对常见细胞系识别率高达90%;已获得15项国内发明专利,3项PCT国际发明专利;产品已经在北大人民医院、北京儿童医院、上海交大附属瑞金医院、上海长海医院、浙江大学附属第一医院、邵逸夫医院、湘雅医院、广州中山大学附属一院等多家医院合作应用。

● 《乘风破浪的姐姐》突然上线,0宣发引爆全网讨论:如果微博还有热搜榜,前20都是姐姐们的
● 破1900亿!特斯拉登顶全球车企市值第一:传统燃油车,要被淘汰了吗?| 撩车
● 博纳影业副总裁凌晨去世,死因未公布,2020年多少电影人走上不归路
● 安徽弯道超车上海?大众狠砸166亿,蔚来70亿被接盘 | 撩车

登录查看更多





